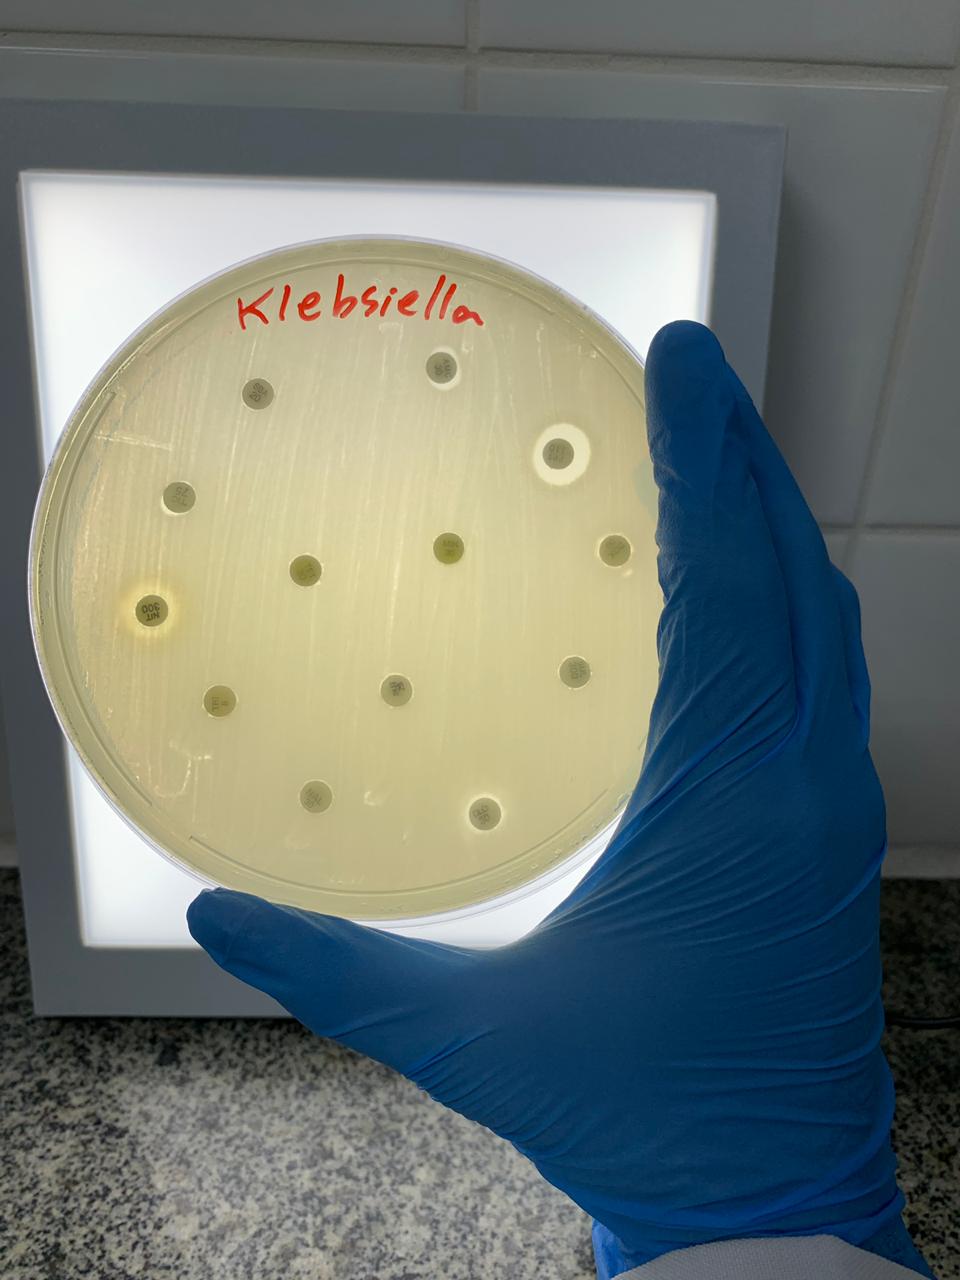

Comemoramos a data com um bate-papo com o assistente técnico da equipe do Vôlei Ribeirão, Gullit Pádua, ex-aluno da Unaerp
O curso de Nutrição da Unaerp oferece uma formação generalista e abrangente, permitindo que o aluno adquira conhecimento sobre todas as fases de produção, elaboração e consumo dos alimentos, desde...
Programação contou com palestra do professor da Universidade, Olavo Augusto Vianna Alves Ferreira
Encontro reuniu integrantes da direção nacional e do conselho deliberativo da entidade e representantes das regionais e segmentos da Faubai
 Unaerp recebe Roadshow Eletrificação sobre Rodas
Unaerp recebe Roadshow Eletrificação sobre RodasEvento da ABB Brasil acontece na próxima quarta-feira, 04/09, no campus Ribeirão
 Dia do Nutricionista é comemorado na Unaerp com palestras de ex-alunas
Dia do Nutricionista é comemorado na Unaerp com palestras de ex-alunas Evento promoveu encontro para discussão acerca de diferentes áreas de atuação da profissão
 Alunos da Unaerp participaram de treinamento durante a 27ª Fenasucro
Alunos da Unaerp participaram de treinamento durante a 27ª FenasucroSeis alunos foram selecionados para a experiência que teve como objetivo incentivar os futuros profissionais para atuação na área de eventos
 Psicologia Unaerp organiza 22º Encontro Acadêmico Científico do curso
Psicologia Unaerp organiza 22º Encontro Acadêmico Científico do cursoO evento contou com palestras, minicursos e apresentações culturais
Professores de Comunicação promoveram uma roda de conversa sobre o tema com alunos da Universidade
Para comemorar a data, entrevistamos a alumini Maria Fernanda Almeida
Pesquisa de docente da Unaerp identifica presença de bactérias multirresistentes fora do ambiente hospitalar
Pesquisa de docente da Unaerp identifica presença de bactérias multirresistentes fora do ambiente hospitalarEstudo analisou um dos microrganismos que mais causa infecções hospitalares e têm desenvolvido maior resistência a antibióticos nos últimos anos
















